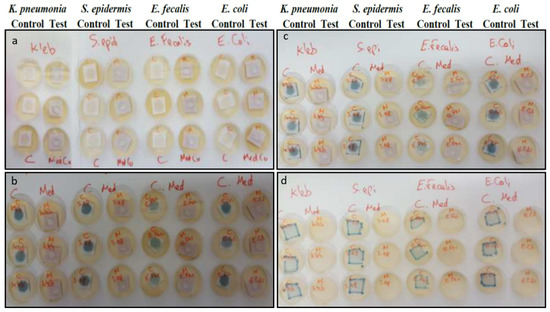
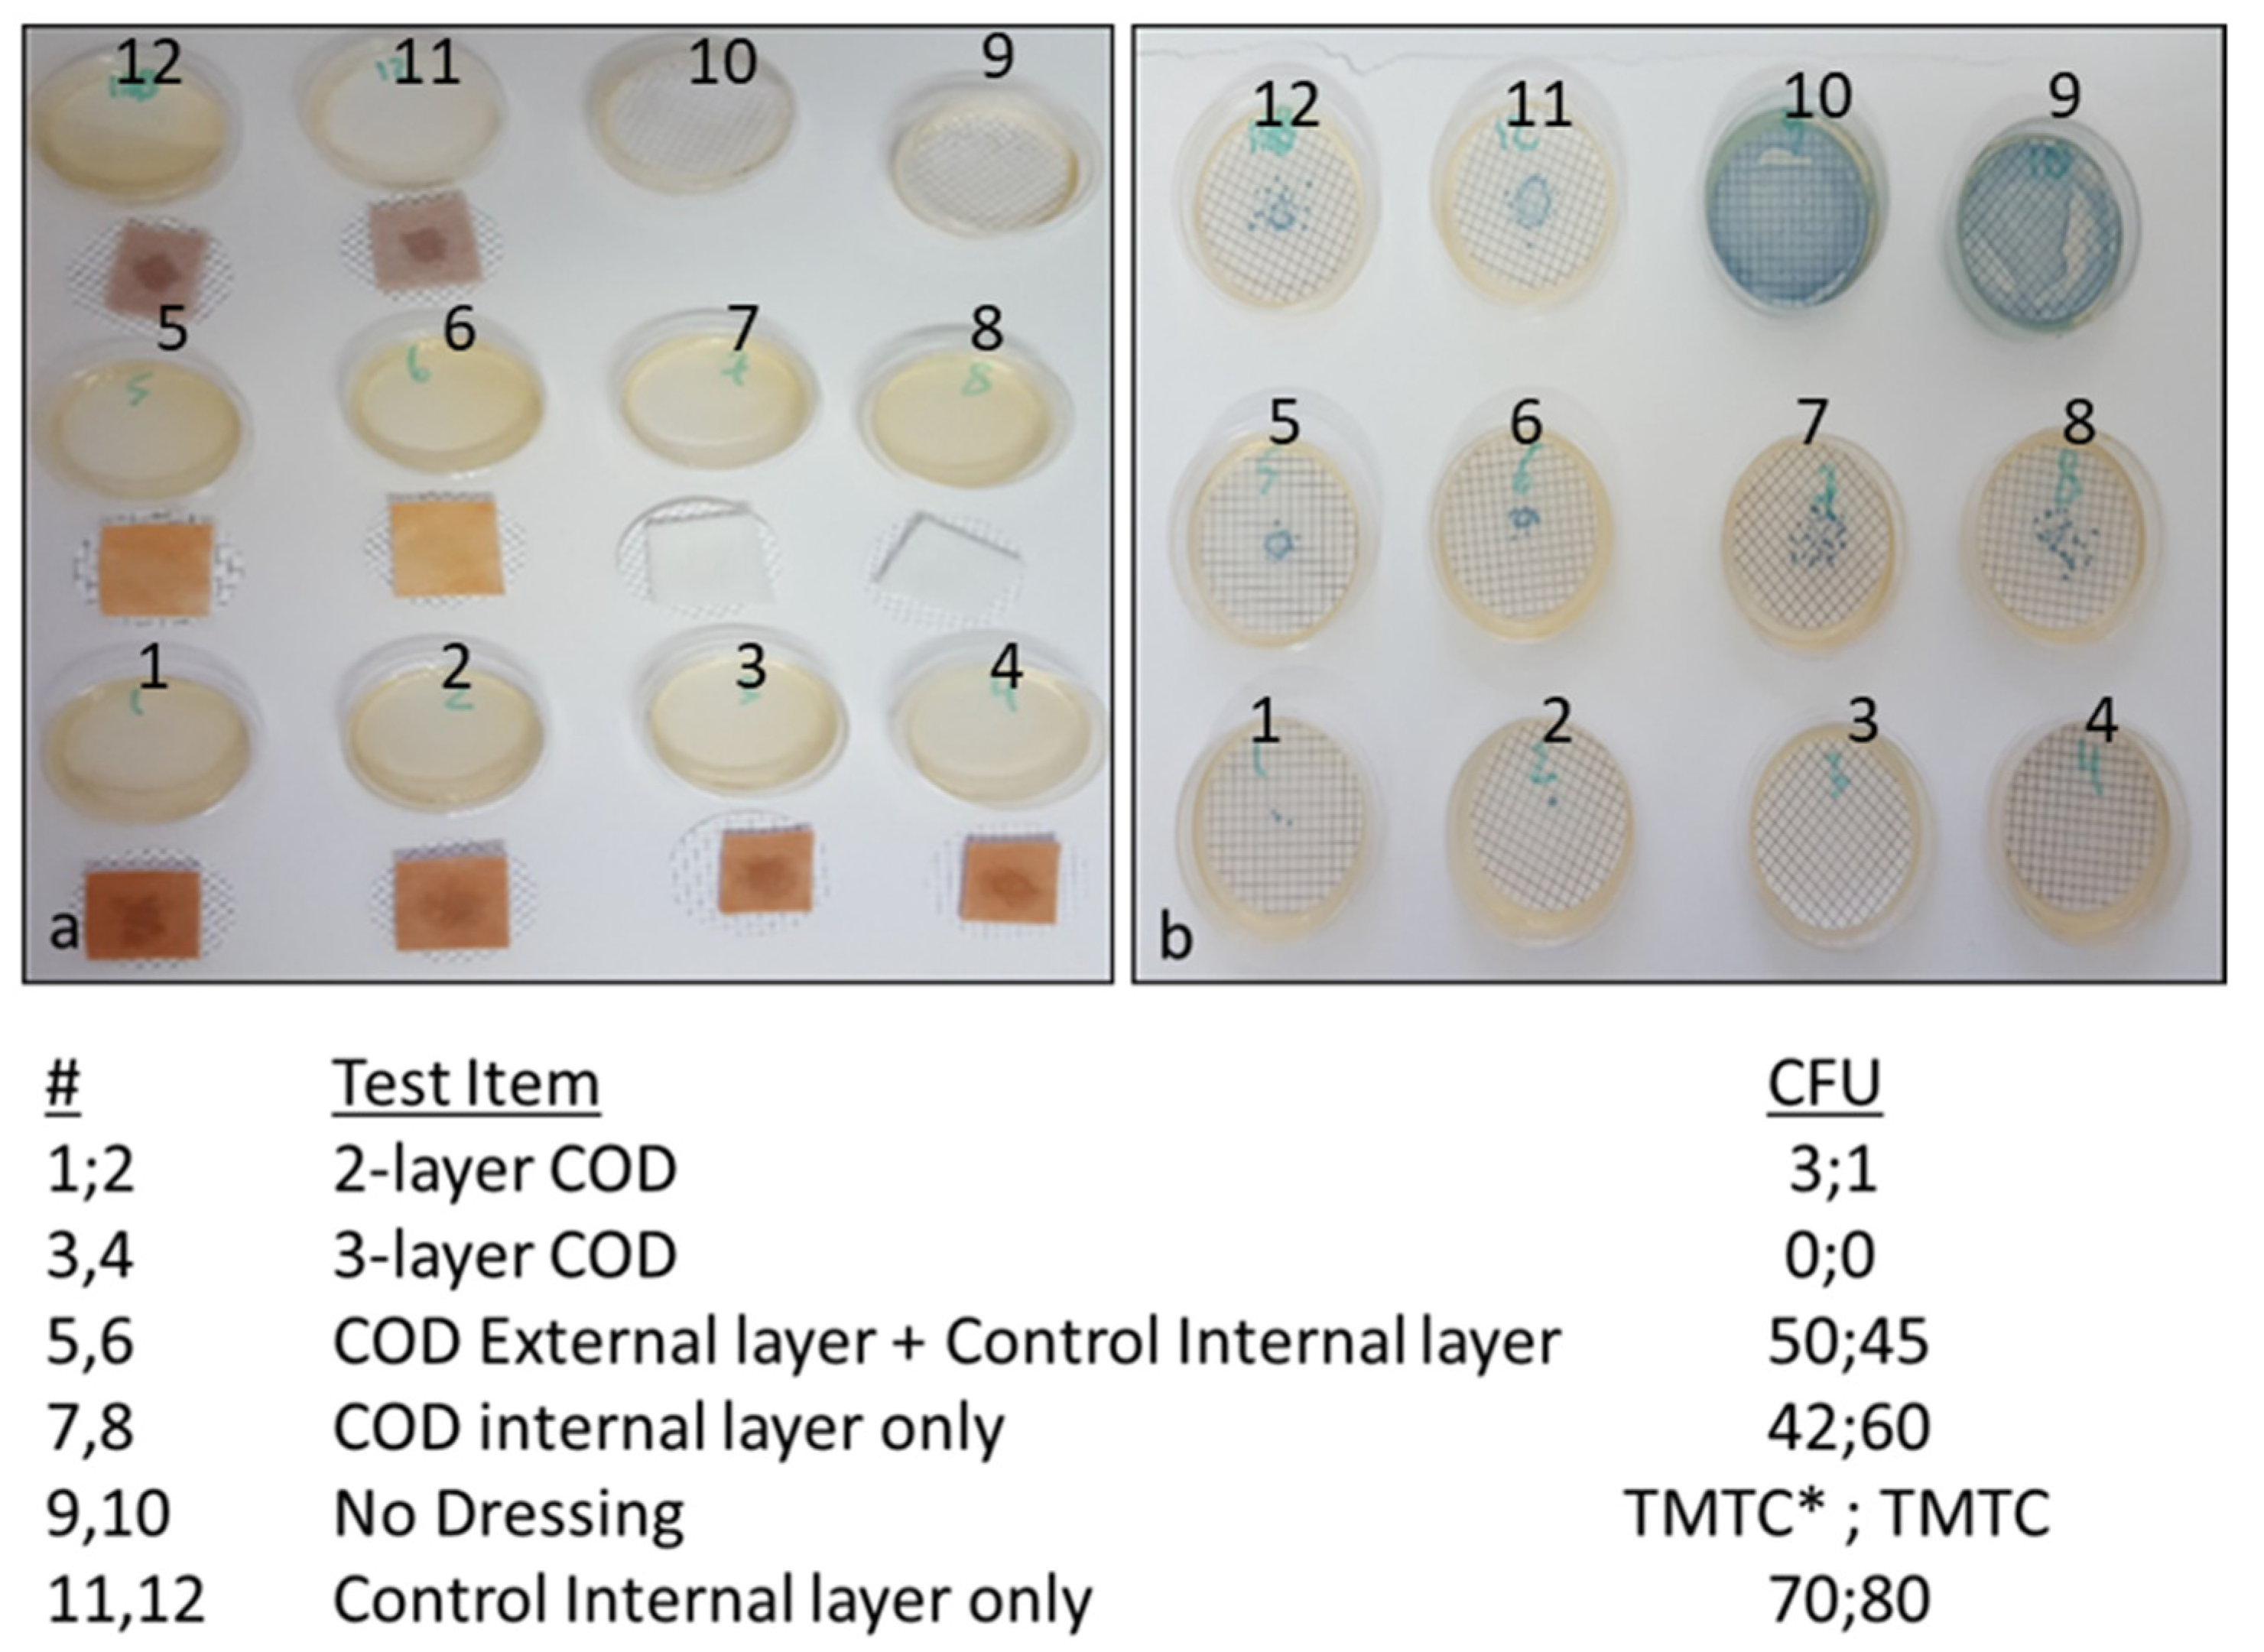
Microbiolres 13 00029 g005

Abstract
Copper has intrinsic antimicrobial properties. Wound dressings impregnated with cuprous oxide microparticles (hereafter termed COD) have been cleared for the management of acute and chronic wounds by the FDA and other regulatory bodies. The COD reduced the viable microbial titers of a wide spectrum of microbes by more than 10,000-fold (4-logs) within 3 h of exposure at 37 °C (p < 0.001). Similar microbial titer reductions were achieved by 3-year naturally aged COD dressings, showing the stability of the biocidal efficacy over time. The potent biocidal efficacy of the COD was maintained even after 7 daily consecutive inoculations of the dressings with ~106 CFU. COD with an adhesive contour blocked the passage of bacteria from the exterior environment to the wound bed side of the dressing even after 7 daily consecutive inoculations of different bacteria on the outer surface of the dressings. Taken together, the study demonstrates the wide spectrum potent in vitro biocidal efficacy of the cuprous oxide impregnated dressings against a wide panel of microorganisms.
1. Introduction
The growth and aging of the world population result in increased occurrence of wounds, including of infected wounds [1]. Wound infections delay significantly the wound healing process via several mechanisms that may prevent the transition from the wound’s inflammatory phase to the wound’s proliferative phase, leading to wound chronicity [2]. Successful treatment of many wound infections has become a difficult task with the increasing prevalence of antibiotic resistant microorganisms [3]. Formation of a microbial biofilm in the wound reduces and may prevent the efficacy of antimicrobial therapy. It has been calculated that one out of 24 surgical interventions will be complicated due to a microbial infection [4]. Wound infections cause a significant burden to patients and to the health care systems [5,6]. Protecting wounds from pathogens is an important clinical practice in the management of wounds, and an important role of wound dressings is to prevent and treat wound infections [3].
Copper is an essential micronutrient for microorganisms. As copper ions can generate reactive oxygen species (ROS), the microorganisms have different ways to control the intracellular copper concentration, mainly by having copper chaperons and efflux specific copper pumps [7,8]. However, when they are exposed to a too high concentration of copper, which varies between microorganisms, they cannot cope with the excess copper and are killed [9,10]. The damage to the microorganisms occurs via several non-specific mechanisms, including plasma membrane permeabilization, membrane lipid peroxidation, damage to nucleic acids and inhibition of the biological assembly and activity of intracellular proteins [11]. The multisite, non-specific copper damaging mechanisms make it very difficult for microorganisms to develop tolerance to copper, and the prevalence of tolerant microorganism to copper is very low [11,12].
Antimicrobial wound dressings are increasingly being used in the management of infected wounds and for the protection of wounds from becoming infected [13]. The development, safety, and biocidal properties of prototype antimicrobial wound dressings containing copper oxide microparticles were previously described [14]. In the current article, we describe the in vitro biocidal activity of significantly improved wound dressings impregnated with cuprous oxide microparticles that have been cleared for use by several regulatory bodies and started recently to be in use for the management of acute and chronic wounds [15,16,17].
2. Materials and Methods
2.1. Test Dressings
Impregnation of cuprous oxide microparticles in polymeric materials and the production of cuprous oxide-impregnated prototype wound dressings were previously described [14,18]. The regulatory cleared cuprous oxide-impregnated dressings (hereafter termed COD) are composed of a highly absorbent layer and one or two external non-binding hydrophilic nonwoven polypropylene layers. All layers are impregnated with cuprous oxide microparticles (Figure 1). The orange layer, which is placed in contact with the wound bed, allows the passage of the wound exudates into the highly absorbent layer. The wound dressings can absorb ~10 times their own weight. The COD with two external layers are more appropriate for application in wound cavities and deep wounds. COD dressings without an adhesive contour can be cut to the shape and size of the wounds. The COD provided with an adhesive contour are more appropriate for post-operative wounds. The COD were examined by scanning electron microscopy (SEM; Jeol JSM-IT100, Japan) and the presence of copper was confirmed by X-ray photoelectron spectrum analysis (built-in system of JEOL), as can be seen in Figure 1.

Figure 1.
Cuprous oxide-impregnated wound dressings. The COD are composed of a highly absorbent layer (beige color) and one or two external non-adherent layers (orange color) (a). The cuprous oxide microparticles embedded in the fibers are the white dots seen in the scanning electronic microscopy images of the orange layer (b) and the absorbent layer (c).
Similar wound dressings (the same construction), but without copper or any other active biocidal component (3M Life Sterile Dressings; Hubei Qianjiang Kingphur Medical Materials Co Ltd., Hubei, China), have been used as negative control dressings. The antimicrobial efficacy of the COD was also compared to the following commercially available antimicrobial wound dressings containing silver: Maxorb extra AG (Medline Industries, Northfield, IL, USA), Puracol Plus (Medline Industries, IL, USA), Optifoam (Medline Industries, IL, USA), Calcium Alginate (McKesson Corporation, Irving, TX, USA), Tegaderm Alginate Ag (3M, Saint Paul, MN, USA), Biatain Alginate Ag (Coloplast, Fredensborg, Denmark), Acticoat Flex 3 (Smith & Nephew, Watford, UK), Mepilex Ag (Mölnlycke Health Care, Gothenburg, Sweden).
2.2. Determination of Log Reduction of Viable Microbial Titers
The antibacterial and antifungal properties of the COD were determined according to the American Association of Textile Chemists and Colorists (AATCC) Test Method 100–1993 [19]. Unless indicated for specific experiments, we applied the following procedure: Six 3.3 cm × 3.3 cm square swatches from each test and control wound dressing were aseptically cut. Each individual swatch was put in the bottom of a sterile plastic vessel. Two mL of sterile 0.85% saline/0.1% Tween 80 (ST; Sigma Aldrich Israel Ltd., Rehovot, Israel) containing wound exudate surrogate (Biological Industries, Beit-Haemek, Israel) solution was added to each swatch, making sure that all liquid was completely absorbed into the control and test swatch samples. Then, 100 µL of a microbial stock assay solution (a fresh test microorganism transplant grown overnight at 37 ± 2 °C in Tryptic soy broth (TBS; Hy laboratories Ltd., Rehovot, Israel) and adjusted to 2–4 × 107 colony forming units (CFU) per mL after being diluted in 5% nutrient broth (NB;Hy laboratories Ltd., Rehovot, Israel) and ST were added to each test swatch sample, making sure that all the liquid was completely absorbed into the control and test samples. Immediately, 100 mL of the neutralizing solution (DeyEngley (D/E) Broth; LAB187, Lab M Limited, Bury, UK) were added to the “Time 0” samples. All other vessels containing the test samples were closed hermetically and put in a 37 °C incubator for 1, 3 (bacteria) or 18 h (Candida albicans). At the end of the incubation, 100 mL of D/E were added to the samples. Immediately (Time 0), or at the end of the incubation, the D/E neutralized swatches were transferred to sterile Stomager bags (Alex Red Ltd. Mevasseret Zion, Israel). The bags were stomached for 2 min and the liquids were returned to the original vessels. From each vessel, 10 µL, 100 µL, and 1 mL of the above recovered liquids were filtered through 0.45 µm Cellulose Nitrate Filters (Sartorious Stedim Biotech GmbH, Göttingen, Germany) by using a Pall filtration device (Pall Corporation, Port Washington, NY, USA). The filters containing the microorganisms were rinsed twice with 100 ± 5 mL of ST and then the membranes were transferred to Petri dishes containing CHROMagar™ Orientation agar (http://www.chromagar.com, accessed 10 May 2022) and incubated at 24 °C (Candida albicans) or 37 °C (bacteria). After 24–48 h of incubation, the CFU were counted. In some experiments, in order to reduce the lower limit of detection from 100 CFU to 10 CFU, 10 mL of each liquid were also filtered. The percent of bacterial or fungal reduction was determined according to the following formula: 100(A − B)/A = %R and the 10-fold reduction was calculated by the following formula: Log A − Log B = Log R to the nearest hundred, where R = 10-fold reduction; A = organism population of the challenge organism; B = the number of test organisms recovered from the inoculated test sample. The test organisms studied are: Methicillin resistant Staphylococcus aureus (MRSA; ATCC BAA-1708); Escherichia coli (ATCC 8739); Klebsiella pneumoniae (ATCC 4352); Enterobacter aerogenes (ATCC 1304); Enterococcus faecalis (ATCC 19439); Pseudomonas aeruginosa (ATCC 15442); Staphylococcus epidermidis (ATCC 12228) and Candida albicans (ATCC 10231). All experiments were performed at least twice and the number of replicates per sample per experiment was at least 3. The means ± standard deviations (SD) of all replicates in all experiments are depicted.
2.3. Determination of COD Microbial Barrier Properties
In order to determine the dressing construction that is capable of reducing significantly the capacity of viable bacteria to pass from the exterior surface to the interior surface of the dressings, several different COD constructions and controls were tested in the study. The test samples included the 2-and 3-layer COD; a dressing composed of the exterior cuprous oxide-impregnated layer and an absorbent internal control layer (without copper); only the internal layer containing cuprous oxide microparticles; and the internal absorbent layer but without copper. Klebsiella pneumoniae, grown overnight with TSB at 37 °C, and diluted in saline to a final concentration of ~800,000 CFU/mL, served as the bacterial inoculum. Duplicate swatches (1.5 cm × 1.5 cm) of each test item were placed on top of sterile cellulose nitrate filters (pore size 0.45 µm, Sartorious Stedim Biotech GmbH, Germany). One mL of the bacterial inoculum was then spiked in the middle area on top of each test item. In parallel, the number of CFU in 1 mL was determined by making serial dilutions and culturing the appropriate dilutions overnight at 37 °C. Ten minutes after the test items were inoculated with the bacteria, the filters were removed and placed on top of agar plates containing CHROMagar™ Orientation agar. The plates were incubated overnight at 37 °C and the number of CFU was then calculated. As an additional control, 1 mL aliquots from the stock bacterial solution were spiked directly on 2 agar plates.
In a similar experiment, triplicate swatches of COD with an adhesive contour and control dressings without copper (3M Life Sterile Dressings) were placed on top of Petri dishes containing CHROMagar™ Orientation agar. The dressings were then spiked with 0.5 mL of 5% NB in saline containing ~2 × 106 microorganisms/mL of the tested microorganism. The inoculation was repeated every 24 h 7 consecutive times. One hour after the 7th inoculation, the wound dressings were removed from the plates and the plates were incubated for 18 h at 37 °C, and the microorganism growth was examined.
3. Results
As can be seen in the graphs presented in Figure 2, the exposure of all the microorganisms to the COD resulted in a dramatic reduction in their viable titer, reaching >10,000-fold reduction (4-logs) at 3 h of incubation as compared to the initial titer, with the exception of Candida albicans that reached the 10,000-fold reduction at 18 h of incubation. In contrast, the titers of all microorganisms exposed to the negative control dressings at 37 °C were either not affected or even increased (negative log reduction) over time.

Figure 2.
Biocidal efficacy of the COD. Each graph shows the mean ± SD fold reduction of at least duplicate experiments per each microorganism tested and per each incubation period. The statistical differences between the microbial titers obtained at each time point between the COD and the negative control dressing were examined by t-tests. * = p < 0.001.
No difference in the biocidal efficacy was found between dressings naturally aged for 7 months, 15 months or 3 years, as shown in a representative experiment in Figure 3.

Figure 3.
Biocidal efficacy of naturally aged COD for 3 years. Swatches of 7 months, 15 months, and 3 years naturally aged 3-layer COD were inoculated with ~2 × 106 CFU of Enterobacter aerogenes. Above 10,000-fold reductions were obtained with all COD tested after 3 h of incubation. The statistical differences in the microbial titers obtained at 3 h of incubation between the negative control and for each naturally aged COD were examined by One Way Analysis of Variance, followed by Holm-Sidak method (a vs. b, p < 0.001). The statistical differences between the microbial titers obtained at 3 h of incubation and the initial titer (0 h) for each naturally aged COD were examined by t-tests. * = p < 0.001; a = mean and standard deviation of the titer retrieved from the Control Dressings at 3 h of incubation; b = mean and standard deviation of the titer retrieved from the COD at 3 h of incubation.
The capacity of the COD to achieve a >10,000-fold reduction in bacterial titers when daily exposed to a high titer of bacteria for 7 consecutive days was examined by inoculating 4 replicate COD swatches daily with ~106 CFU of Klebsiella pneumoniae. Then, three hours after the 7th bacterial inoculation, the bacteria were retrieved from the COD and control dressing swatches and the CFU were determined after 24 h of incubation at 37 °C. While in the control samples the CFU was ~106, no CFU were recovered from all 4 COD swatches, demonstrating an above 10,000-fold reduction in the viable bacterial titer (Figure 4).

Figure 4.
Potent biocidal efficacy of the test dressings after consecutive multiple bacterial exposures. Four control dressings and four test dressings were spiked with ~106 CFU of Klebsiella pneumoniae daily seven consecutive times. After each first six daily bacterial inoculations of the swatches, the swatches were incubated for 24 h at 37 °C. After the 7th bacterial inoculation on Day 7, the swatches were incubated for 3 h at 37 °C and then the bacteria were recovered by filtering 10 µL, 100 µL, and 1 mL of the stomached microbial solution. The CFU of the surviving bacteria were then determined after 24 h of incubation at 37 °C. A representative example of the CFU obtained from a control dressing swatch and a COD swatch is shown. The spiked and mean recovered bacterial titers on Day 7 are depicted in the bar graph. The statistical differences between the spiked microbial CFU titers (before) and the recovered CFU (after) were examined by a t-test. * = p < 0.001.
We also compared the antimicrobial efficacy of the COD against several antimicrobial commercially available wound dressings containing silver by spiking the dressings with high microorganism titers. After 1 h of incubation at 37 °C, the microorganisms were retrieved, and their viability was determined as described in the Section 2. While the COD as well as Mepilex Ag and Acticoat Ag demonstrated good biocidal efficacy against the tested microorganisms, as no viable microorganisms were recovered after 1 h of incubation, the other tested dressings showed significantly lower biocidal efficacy (Table 1).

Table 1.
Antimicrobial comparison between the COD and antimicrobial commercially available wound dressings containing silver. The initial titers spiked onto the dressings and the recovered viable titers after 1 h of incubation at 37 °C are detailed (mean ± SD). * Lower limit of detection.
In order to determine the capacity of the various COD constructions without an adhesive contour to reduce the passage of bacteria from the exterior environment to the wound bed, the swatches of various test items, as described in the Section 2 and as shown in Figure 5, were spiked with 1 mL containing ~8 × 105 CFU of Klebsiella pneumoniae. As can be seen in Figure 5, a similar number of bacteria passed through the COD internal layer only, the COD external layer only and control internal layer alone, and the control internal layer alone without cuprous oxide microparticles. However, through the 2-layer COD only 1 and 3 viable bacteria, and from the 3-layer COD no viable bacteria, passed from one side of the fabric to the other side.

Figure 5.
Reduction of bacterial passage through the COD without an adhesive contour. (a) The test items were placed on top of cellulose nitrate filters as detailed in the left column of the Figure and spiked with 1 mL of ~8 × 105 CFU of Klebsiella pneumoniae in the middle of each swatch (dark spot seen in each swatch). After 10 min, the test items were removed and the filters were placed on top of agar plates. As control of the inoculated bacterial load, 2 agar plates were inoculated with 1 mL of the Klebsiella pneumoniae stock solution (plates 9 and 10). (b) After overnight incubation at 37 °C, the CFU on each plate were counted. The numbers of CFU per each duplicate sample tested are shown in the right column of the Figure. TMTC: Too many to count.
Figure 6 depicts the capacity of the COD with an adhesive contour to block the passage of bacteria from the exterior environment to the wound bed even after 7 daily consecutive inoculations of different representative gram-negative and gram-positive bacteria on the outer surface of the dressings. After the 7th and last bacterial inoculation, and after wound dressings were removed from the agar, no growth was observed on the agar plates under the removed tested COD. In contrast, bacterial growth was observed on the agar under all the control wound dressings (Figure 6).
Figure 6.
Blockade of bacterial passage through the COD with an adhesive contour. (a) First inoculation of the different bacteria onto the Control and COD dressings. Agar plates were covered with swatches of the Control or COD dressings (triplicates). Each swatch was then inoculated with 0.5 mL containing ~106 CFU of the specified microorganisms and incubated overnight at 37 °C. This inoculation and incubation process on the same dressing swatches was repeated 7 consecutive times. (b) Representative pictures showing growth of all 4 tested bacteria after 18 h of the first bacterial inoculation only under the control wound dressings, indicating that the bacteria were able to pass only through the control dressing onto the agar plate, and not through the COD. (c) Representative pictures showing growth of all 4 tested bacteria after the 6th bacterial inoculation only under the control wound dressings. (d) After the 7th and last bacterial inoculation and 18 h of incubation at 37 °C, the wound dressings were removed from the agar. As can be seen, bacteria grew only on the agar plates on which the control dressings were present and not under the COD. C = Control Dressings; Med = COD dressings.
4. Discussion
Wound dressings impregnated with cuprous oxide microparticles have been cleared by the USA FDA (510(k) K180643), EU and other regulatory bodies worldwide to be used in the management of acute and chronic wounds, after their biocompatibility, safety, and efficacy were demonstrated. These wound dressings have already been in clinical use for more than 2 years in several geographies, enhancing wound healing of both infected and non-infected wounds, including chronic wounds [15,16,17].
The data obtained in our study clearly indicate that COD possess a strong biocidal activity against a broad spectrum of bacteria on the dressings and confer protection to the wounds from external microbial contamination.
Cuprous oxide microparticles were chosen as the active biocidal ingredient to be used in the COD dressings for two main reasons: they have very powerful wide spectrum biocide properties (e.g., [20]), and they are non-soluble copper particles. The cuprous oxide microparticles serve as a reservoir of copper ions that are slowly and constantly released [16,21], endowing the wound dressing with prolonged and stable biocidal properties for at least 7 consecutive days that protect the dressings from bio-contamination and reduction of passage of the viable microorganism through them from the exterior environment into the wound bed.
The potent biocidal efficacy of the dressings was proved against both gram-positive and gram-negative bacteria, including against MRSA, an antibiotic-resistant bacterium. The bacteria that we choose to use in our antimicrobial tests are known wound pathogens [22,23]. In some of the experiments we chose to test the antimicrobial efficacy of the COD against Enterobacter aerogenes and Klebsiella pneumoniae as representative microorganisms (Figure 3, Figure 4 and Figure 5), because these bacteria produce blue colonies when using CHROMagar™ Orientation agar that are easy to count for determining the CFU. In order to be able to demonstrate at least 10,000-fold reductions, we inoculated the dressings with an initial inoculum titer of ~106 CFU, and the lower limit of detection was 102 CFU, allowing us to detect up to 10,000-fold microbial titer reductions. Indeed, with all bacteria tested, ≥10,000-fold titer reductions were achieved within 3 h of the bacterial exposure to the dressings. Even after 7 consecutive daily spikings of the COD to high bacterial titers, a 10,000-fold reduction was achieved after the 7th bacterial inoculation, indicating that the amount of cuprous oxide microparticles in the dressings is sufficient to endow the dressings with prolonged potent biocidal efficacy. The reason we chose to inoculate the dressings for 7 consecutive days was because each individual COD is cleared to be used on a wound for up to 7 days by the regulatory bodies. A longer exposure time was required to achieve 10,000-fold reduction against Candida albicans. Yeast and fungi seem to be less sensitive to copper exposure than bacteria [24]. It should be mentioned that the lower limit of detection of most assays was 100 CFU (2-logs). Therefore, when no CFU were found, the number of bacteria recovered was considered to be ≤100 CFU. Since the initial inoculum was ~106 CFU, the maximum fold reduction detected in these cases was ≥10,000. The exact 10-fold reduction may have been significantly higher as was indeed the case in several experiments (data not shown).
Today most antimicrobial dressings in clinical use contain silver, as silver also has antimicrobial properties. However, there are increasing reports of potential wound-healing inhibition and toxicity by silver dressings [25,26,27,28,29]. In our hands, the COD showed significantly better antimicrobial efficacy than most commercially available antimicrobial wound dressings containing silver that we tested (Table 1), indicating that the potential of the COD to confer antimicrobial protection in clinical use is not less and most probably greater than most currently clinically used silver dressings.
The COD have two basic layers. A highly absorbent layer capable of absorbing ~10 times its own weight (data not shown). This allows the absorption of the wound exudates, which is mainly secreted from infected wounds. As wound exudate management is important for allowing wound healing processes to occur, the capacity to absorb and retain wound exudates is an important wound-dressing attribute [30,31]. The presence of the cuprous oxide microparticles in this layer prevents the proliferation of the absorbed bacteria secreted from the wound, suggesting reducing the risk of cross-contamination and foul odor. The second layer is a thin, non-stick, non-woven fabric that allows the passage of the wound’s exudate to the absorbent layer, while also allowing easier removal from the wound bed of the dressing after its use. This layer, which also contains cuprous oxide microparticles, additionally enhances the capacity of the dressings to prevent the passage of viable bacteria from the exterior to the wound bed (Figure 5). In one of the COD constructions, used mainly to manage wound cavities and wound tunnels, this thin nonwoven layer is present on both sides of the absorbent fabric, in order to prevent the wound dressings from adhering to the surrounding wound bed. The COD with an adhesive contour also confer a mechanical barrier for at least 7 days from microbial contamination (Figure 6). The described COD have significantly better properties than the prototypes previously described [14]— they have significantly better biocidal properties and better exudate management properties, and the COD with an adhesive contour also serves as a mechanical barrier to microbial contamination.
Taken together, the data obtained in the study, demonstrate the high broad spectrum and prolonged biocidal and wound microbial protection efficacy of wound dressings impregnated with cuprous oxide microparticles as well as the potential to manage infected wounds with COD.
Author Contributions
G.B. designed the studies. A.K. and T.R. performed the experiments. All authors contributed to the writing of the manuscript. All authors have read and agreed to the published version of the manuscript.
Funding
This research received no external funding.
Institutional Review Board Statement
Not applicable.
Informed Consent Statement
Not applicable.
Data Availability Statement
Not applicable.
Conflicts of Interest
G.B. is the Chief Scientist of MedCu. T.R. is a current employee of MedCu. A.K. was previously employed by MedCu. MedCu is the company that developed the COD.
References
- Malone, M.; Schultz, G. Challenges in the diagnosis and management of wound infection. Br. J. Dermatol. 2022. [Google Scholar] [CrossRef]
- Maheswary, T.; Nurul, A.A.; Fauzi, M.B. The Insights of Microbes’ Roles in Wound Healing: A Comprehensive Review. Pharmaceutics 2021, 13, 981. [Google Scholar] [CrossRef]
- Anon. Wound infection in clinical practice. An international consensus. Int. Wound J. 2008, 5 (Suppl. 3), iii-11. [Google Scholar] [CrossRef] [PubMed]
- Johnson, A.C. Wound infection: A review of qualitative and quantitative assessment modalities. J. Plast. Reconstr. Aesthetic Surg. 2022, 75, 1287–1296. [Google Scholar] [CrossRef] [PubMed]
- Hrynyshyn, A.; Simoes, M.; Borges, A. Biofilms in Surgical Site Infections: Recent Advances and Novel Prevention and Eradication Strategies. Antibiotics 2022, 11, 69. [Google Scholar] [CrossRef] [PubMed]
- Badia, J.M.; Casey, A.L.; Petrosillo, N.; Hudson, P.M.; Mitchell, S.A.; Crosby, C. Impact of surgical site infection on healthcare costs and patient outcomes: A systematic review in six European countries. J. Hosp. Infect. 2017, 96, 1–15. [Google Scholar] [CrossRef] [PubMed] [Green Version]
- Rademacher, C.; Masepohl, B. Copper-responsive gene regulation in bacteria. Microbiology 2012, 158 Pt 10, 2451–2464. [Google Scholar] [CrossRef]
- Dennison, C.; David, S.; Lee, J. Bacterial copper storage proteins. J. Biol. Chem. 2018, 293, 4616–4627. [Google Scholar] [CrossRef] [PubMed] [Green Version]
- Borkow, G. Using copper to fight microorganisms. Curr. Chem. Biol. 2012, 6, 93–103. [Google Scholar] [CrossRef]
- Reyes-Jara, A.; Cordero, N.; Aguirre, J.; Troncoso, M.; Figueroa, G. Antibacterial Effect of Copper on Microorganisms Isolated from Bovine Mastitis. Front. Microbiol. 2016, 7, 626. [Google Scholar] [CrossRef] [PubMed] [Green Version]
- Borkow, G.; Gabbay, J. Copper as a biocidal tool. Curr. Med. Chem. 2005, 12, 2163–2175. [Google Scholar] [CrossRef] [PubMed] [Green Version]
- Giachino, A.; Waldron, K.J. Copper tolerance in bacteria requires the activation of multiple accessory pathways. Mol. Microbiol. 2020, 114, 377–390. [Google Scholar] [CrossRef] [PubMed]
- Simoes, D.; Miguel, S.P.; Ribeiro, M.P.; Coutinho, P.; Mendonca, A.G.; Correia, I.J. Recent advances on antimicrobial wound dressing: A review. Eur. J. Pharm. Biopharm. 2018, 127, 130–141. [Google Scholar] [CrossRef] [PubMed]
- Orkow, G.; Okon-Levy, N.; Gabbay, J. Copper oxide impregnated wound dressings: Biocidal and safety studies. Wounds 2010, 22, 310–316. [Google Scholar]
- Borkow, G.; Melamed, E. Copper, an abandoned player returning to the wound healing battle. In Recent Advances in Wound Healing, 1st ed.; Shahin, A., Ed.; IntechOpen: London, UK, 2021. [Google Scholar] [CrossRef]
- Melamed, E.; Kiambi, P.; Okoth, D.; Honigber, I.; Tamir, E.; Borkow, G. Healing of Chronic Wounds by Copper Oxide-Impregnated Wound Dressings-Case Series. Medicina 2021, 57, 296. [Google Scholar] [CrossRef]
- Melamed, E.; Rovitsky, A.; Roth, T.; Assa, L.; Borkow, G. Stimulation of Healing of Non-Infected Stagnated Diabetic Wounds by Copper Oxide-Impregnated Wound Dressings. Medicina 2021, 57, 1129. [Google Scholar] [CrossRef] [PubMed]
- Borkow, G.; Gabbay, J. Putting copper into action: Copper-impregnated products with potent biocidal activities. FASEB J. 2004, 18, 1728–1730. [Google Scholar] [CrossRef] [PubMed]
- AATCC Test Method 100-2004; AATCC Technical Manual. American Association of Textile Chemists and Colorists: Research Triangle Park, NC, USA, 2006; pp. 149–151.
- Popov, S.; Saphier, O.; Popov, M.; Shenker, M.; Entus, S.; Shotland, Y.; Saphier, M. Factors Enhancing the Antibacterial Effect of Monovalent Copper Ions. Curr. Microbiol. 2020, 77, 361–368. [Google Scholar] [CrossRef]
- Neel, E.A.; Ahmed, I.; Pratten, J.; Nazhat, S.N.; Knowles, J.C. Characterisation of antibacterial copper releasing degradable phosphate glass fibres. Biomaterials 2005, 26, 2247–2254. [Google Scholar] [CrossRef]
- Rahim, K.; Saleha, S.; Zhu, X.; Huo, L.; Basit, A.; Franco, O.L. Bacterial Contribution in Chronicity of Wounds. Microb. Ecol. 2017, 73, 710–721. [Google Scholar] [CrossRef]
- Wong, S.Y.; Manikam, R.; Muniandy, S. Prevalence and antibiotic susceptibility of bacteria from acute and chronic wounds in Malaysian subjects. J. Infect. Dev. Ctries. 2015, 9, 936–944. [Google Scholar] [CrossRef] [Green Version]
- Borkow, G.; Salvatori, R.; Kanmukhla, V.K. Drastic Reduction of Bacterial, Fungal and Viral Pathogen Titers by Cuprous Oxide Impregnated Medical Textiles. J. Funct. Biomater. 2021, 12, 9. [Google Scholar] [CrossRef] [PubMed]
- Burd, A.; Kwok, C.H.; Hung, S.C.; Chan, H.S.; Gu, H.; Lam, W.K.; Huang, L. A comparative study of the cytotoxicity of silver-based dressings in monolayer cell, tissue explant, and animal models. Wound Repair Regen. 2007, 15, 94–104. [Google Scholar] [CrossRef] [PubMed]
- Dumville, J.C.; Lipsky, B.A.; Hoey, C.; Cruciani, M.; Fiscon, M.; Xia, J. Topical antimicrobial agents for treating foot ulcers in people with diabetes. Cochrane Database Syst. Rev. 2017, 6, CD011038. [Google Scholar] [CrossRef] [PubMed]
- Poon, V.K.; Burd, A. In vitro cytotoxity of silver: Implication for clinical wound care. Burns 2004, 30, 140–147. [Google Scholar] [CrossRef] [PubMed]
- Fuller, F.W. The side effects of silver sulfadiazine. J. Burn Care Res. 2009, 30, 464–470. [Google Scholar] [CrossRef]
- Trop, M.; Novak, M.; Rodl, S.; Hellbom, B.; Kroell, W.; Goessler, W. Silver-coated dressing acticoat caused raised liver enzymes and argyria-like symptoms in burn patient. J. Trauma 2006, 60, 648–652. [Google Scholar] [CrossRef]
- Tickle, J. Wound exudate assessment and management: A challenge for clinicans. Br. J. Nurs 2015, 24 (Suppl. S20), S38–S43. [Google Scholar] [CrossRef]
- Chamanga, E. Effectively managing wound exudate. Br. J. Community Nurs. 2015, 20 (Suppl. S9), S8–S10. [Google Scholar] [CrossRef]
Publisher’s Note: MDPI stays neutral with regard to jurisdictional claims in published maps and institutional affiliations. |
© 2022 by the authors. Licensee MDPI, Basel, Switzerland. This article is an open access article distributed under the terms and conditions of the Creative Commons Attribution (CC BY) license (https://creativecommons.org/licenses/by/4.0/).